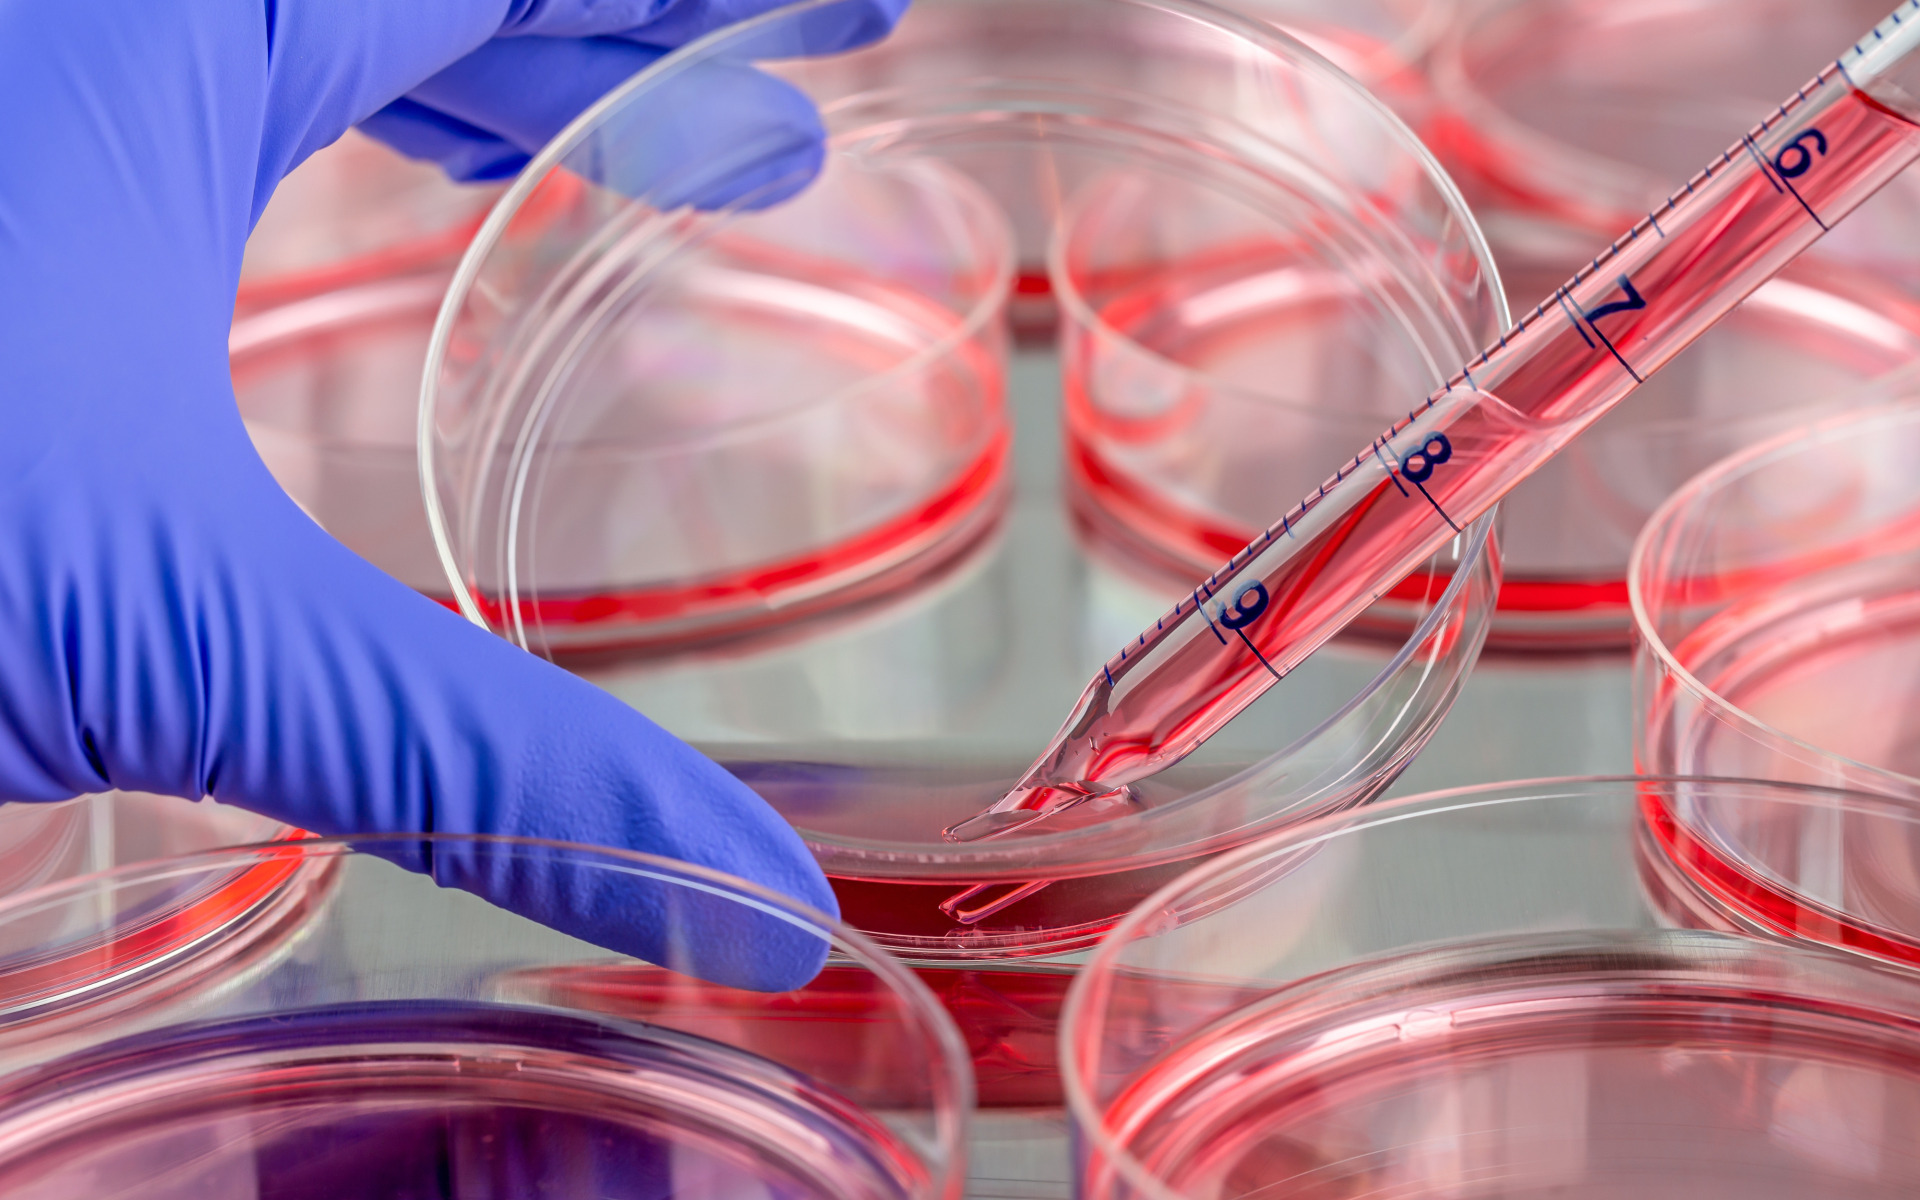

World of Laboratory
The World of Laboratory brings together all relevant topics for laboratories in industry, healthcare, and research. Exhibitors will inform you about the latest solutions, from layout and equipment to analytical instruments and chemicals. The program of seminars, workshops, expert sessions, round table discussions, and X-peditions is designed to inspire and provide practical tips. Attend lectures and workshops on quality, safety, analytical techniques, sustainability, and sample management.
Sign up for a free visit to the World of Laboratory